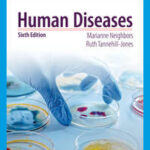
Human Diseases

Original price was: $141.89.$105.10Current price is: $105.10. This product page includes key details such as author, publisher, ISBN, edition, binding, and condition. Please refer to the product details above for the most accurate information about this title. NEW10 Payment Methods:
Becoming a Critical Thinker
Publisher
Author
Format
Description

Welcome to Mazi Books

ISBN: 9781285438597
Edition: Unknown
Condition: New
Language: en
Publication date: 2014-01-01
Page: 208
4
People watching this product now!
Take 10% OFF your first purchase.

Reviews
There are no reviews yet.